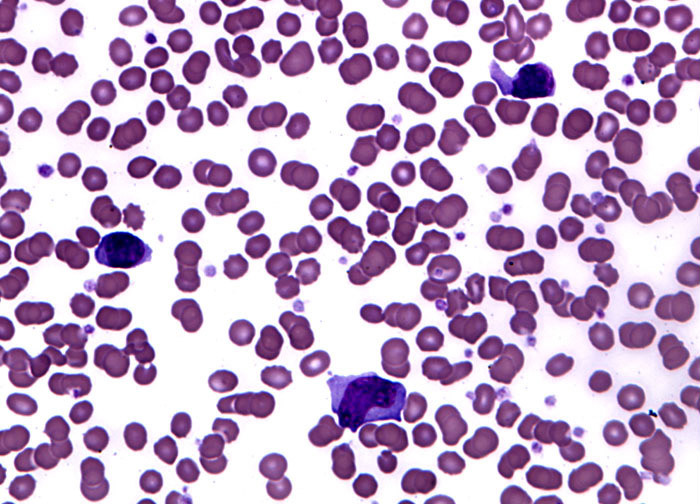

Virusi su acelularni, ultramikroskopski, organizmi nesposobni da se razmnožavaju van ćelije domaćina. Izvan ćelije domaćina one ne pokazuju osobine živih bića, čak mogu i da kristalizuju. Kristalizovani virusi zadržavaju sposobnost infekcije. Zrela virusna, vanćeliska, čestica sposobna da inficira ćeliju naziva se virion. Ulaskom u ćeliju virion postaje aktivan tj. virus. Virus u ćeliji preuzima kontrolu nad molekularnim aparatom i koristi ga za sopstveno razmnožavanje.
Analize za mononukleozu
Analize za HIV
- Vađenje krvi
- HIV 1+2(ag/at)
Ćelija domaćina tada stvara delove virusa, a ne materije koje su njoj potrebne za normalan rad. To u domaćinu dovodi do patoloških stanja (bolesti), pa se virusi smatraju isključivim unutarćeliskim – obligatnim parazitima.
Oboljenja uzrokovana virusima
Mnoga oboljenja izazvana su virusima:
- Žutica – Hepatitis (B, C, A)
- Kondilomi – bradavice
- Mononukleoza – “bolest poljupca” – zbog načina prenošenja
- Male boginje
- Velike boginje
- kijavica
- grip
- zauške
- varičela
- rubeola
Neke eukariotske ćelije inficirane virusom imaju sposobnost stvaranja proteina nazvanog interferon.
Interferon
Ovaj protein sprečava, blokira replikaciju virusa. Interferon se oslobađa iz inficiranihćelija i veoma dobro štiti susedne ćelije. Stvaranje interferona naziva se interferencija (ometanje virusa). Interferon, proizveden kao odgovorna jednu virusnu infekciju, pruža ćeliji zaštitu od sledećih infekcija, čak i od drugih različitih vrsta virusa. Vakcine (koje se koriste u pokretanju odbrambenih mehanizama ćelije protiv virusa) obično sadrže mrtve viruse ili virusnu nukleinsku kiselinu koje pokreću proizvodnju interferona.
Pre 1980. god. interferon se izdvajao iz humanih (ljudskih) ćelija što je bilo skupo, a danas se proizvodi genetičkim inženjeringom, što je znatno jeftinije. Ovim načinom se ljudski gen za interferon ugradi u genom bakterija koje tada proizvode taj protein.